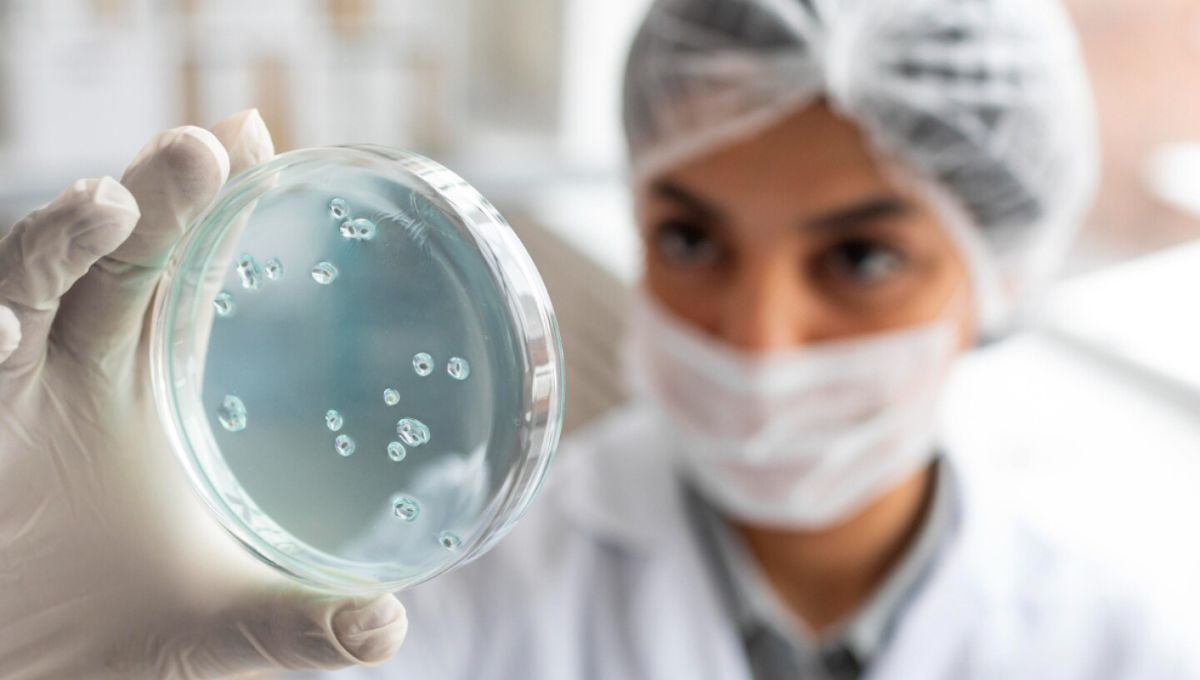
El virus mortal que vuelve a preocupar: no hay vacuna y se contagia a través de personas, frutas y animales

Hay un virus, no tan viejo, que nuevamente ha logrado que la comunidad científica tenga una cierta preocupación sobre él. Se trata del virus Nipah.
El virus mortal que vuelve a preocupar: no hay vacuna y se contagia a través de personas, frutas y animales
La comunidad ecientífica está preocupada por un virus que fue descubierto en 1999 y que no tiene vacuna. Los síntomas
Este virus nació o, al menos, tuvo su primer caso conocido en 1999, en la aldea de Nipah, en India. Se trata de una enfermedad causada por la misma familai de virus que el sarampión, es menos contagiosa, pero más mortal.
Recomendadas
Los síntomas que causa este virus pueden tardar entre cuatro y catorce días en aparecer tras la infección y los casos asintomáticos son poco frecuentes. Esto lleva a que haya personas que contagien sin saber que están contagiadas.
El virus está clasificado por los CDC como de nivel cuatro de bioseguridad que es la categoría más alta, con los patógenos más peligrosos como los del ébola y tiene el potencial de servir como agente de bioterrorismo.
Si bien se registraron pocos brotes, el virus Nipah se considera una amenaza para la salud pública debido a su alta tasa de mortalidad, su potencial de transmisión entre personas, su capacidad de causar brotes y la falta de vacunas o tratamientos aprobados.
Cómo se contagia el virus Nipah
El virus Nipah es zoonótico, es decir, que se puede transmitirse de animales a humanos y esto ocurre con mayor frecuencia a través del contacto directo con un cerdo o murciélago infectado, según los Centros para el Control y la Prevención de Enfermedades de Estados Unidos (CDC, en inglés).
Además, el consumo de frutas o productos derivados de frutas, como el jugo crudo de dátil, contaminados con orina o saliva de murciélagos frugívoros infectados también contribuye a la propagación, mientras que también puede transmitirse directamente de persona a persona.
Para diagnosticarlo se suelen realizar pruebas con una muestra de sangre para detectar y cuantificar proteínas específicas, mientras que, al no existir una vacuna ni un medicamento específico para este virus, los médicos llaman a la prevención.